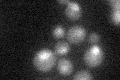
YDR362C
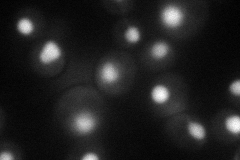
YDR362C
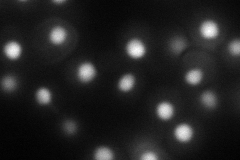
YDR362C
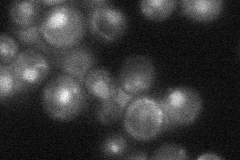
YDR362C

View description
One of six subunits of RNA polymerase III transcription initiation factor complex (TFIIIC); part of TFIIIC TauB domain that binds BoxB promoter sites of tRNA and other genes; cooperates with Tfc3p in DNA binding; human homolog is TFIIIC-110
Localization:
Intensity:
Fold change:
Significance:
-
C’ GFP library in SD
nucleus23.69 -
N' NOP1pr-GFP in SD
nucleus56.3674 -
N' TEF2pr-mCherry in SD
nucleus70.3692 -
N' NATIVEpr-GFP in SD
nucleus25.1375 -
N' TEF2pr-VC and Cyto-VN in SD

#N/A0 -
C’ GFP library in SD+DTT

nucleus24.111.01No -
C’ GFP library in SD+H2O2

nucleus25.971.09No -
C’ GFP library in Starvation Media

nucleus19.530.82No -
C’ GFP library on the background of Pup2-DaMP

nucleus -
C’ GFP library on the background of CCT mutant

nucleus23.73531.00157No
